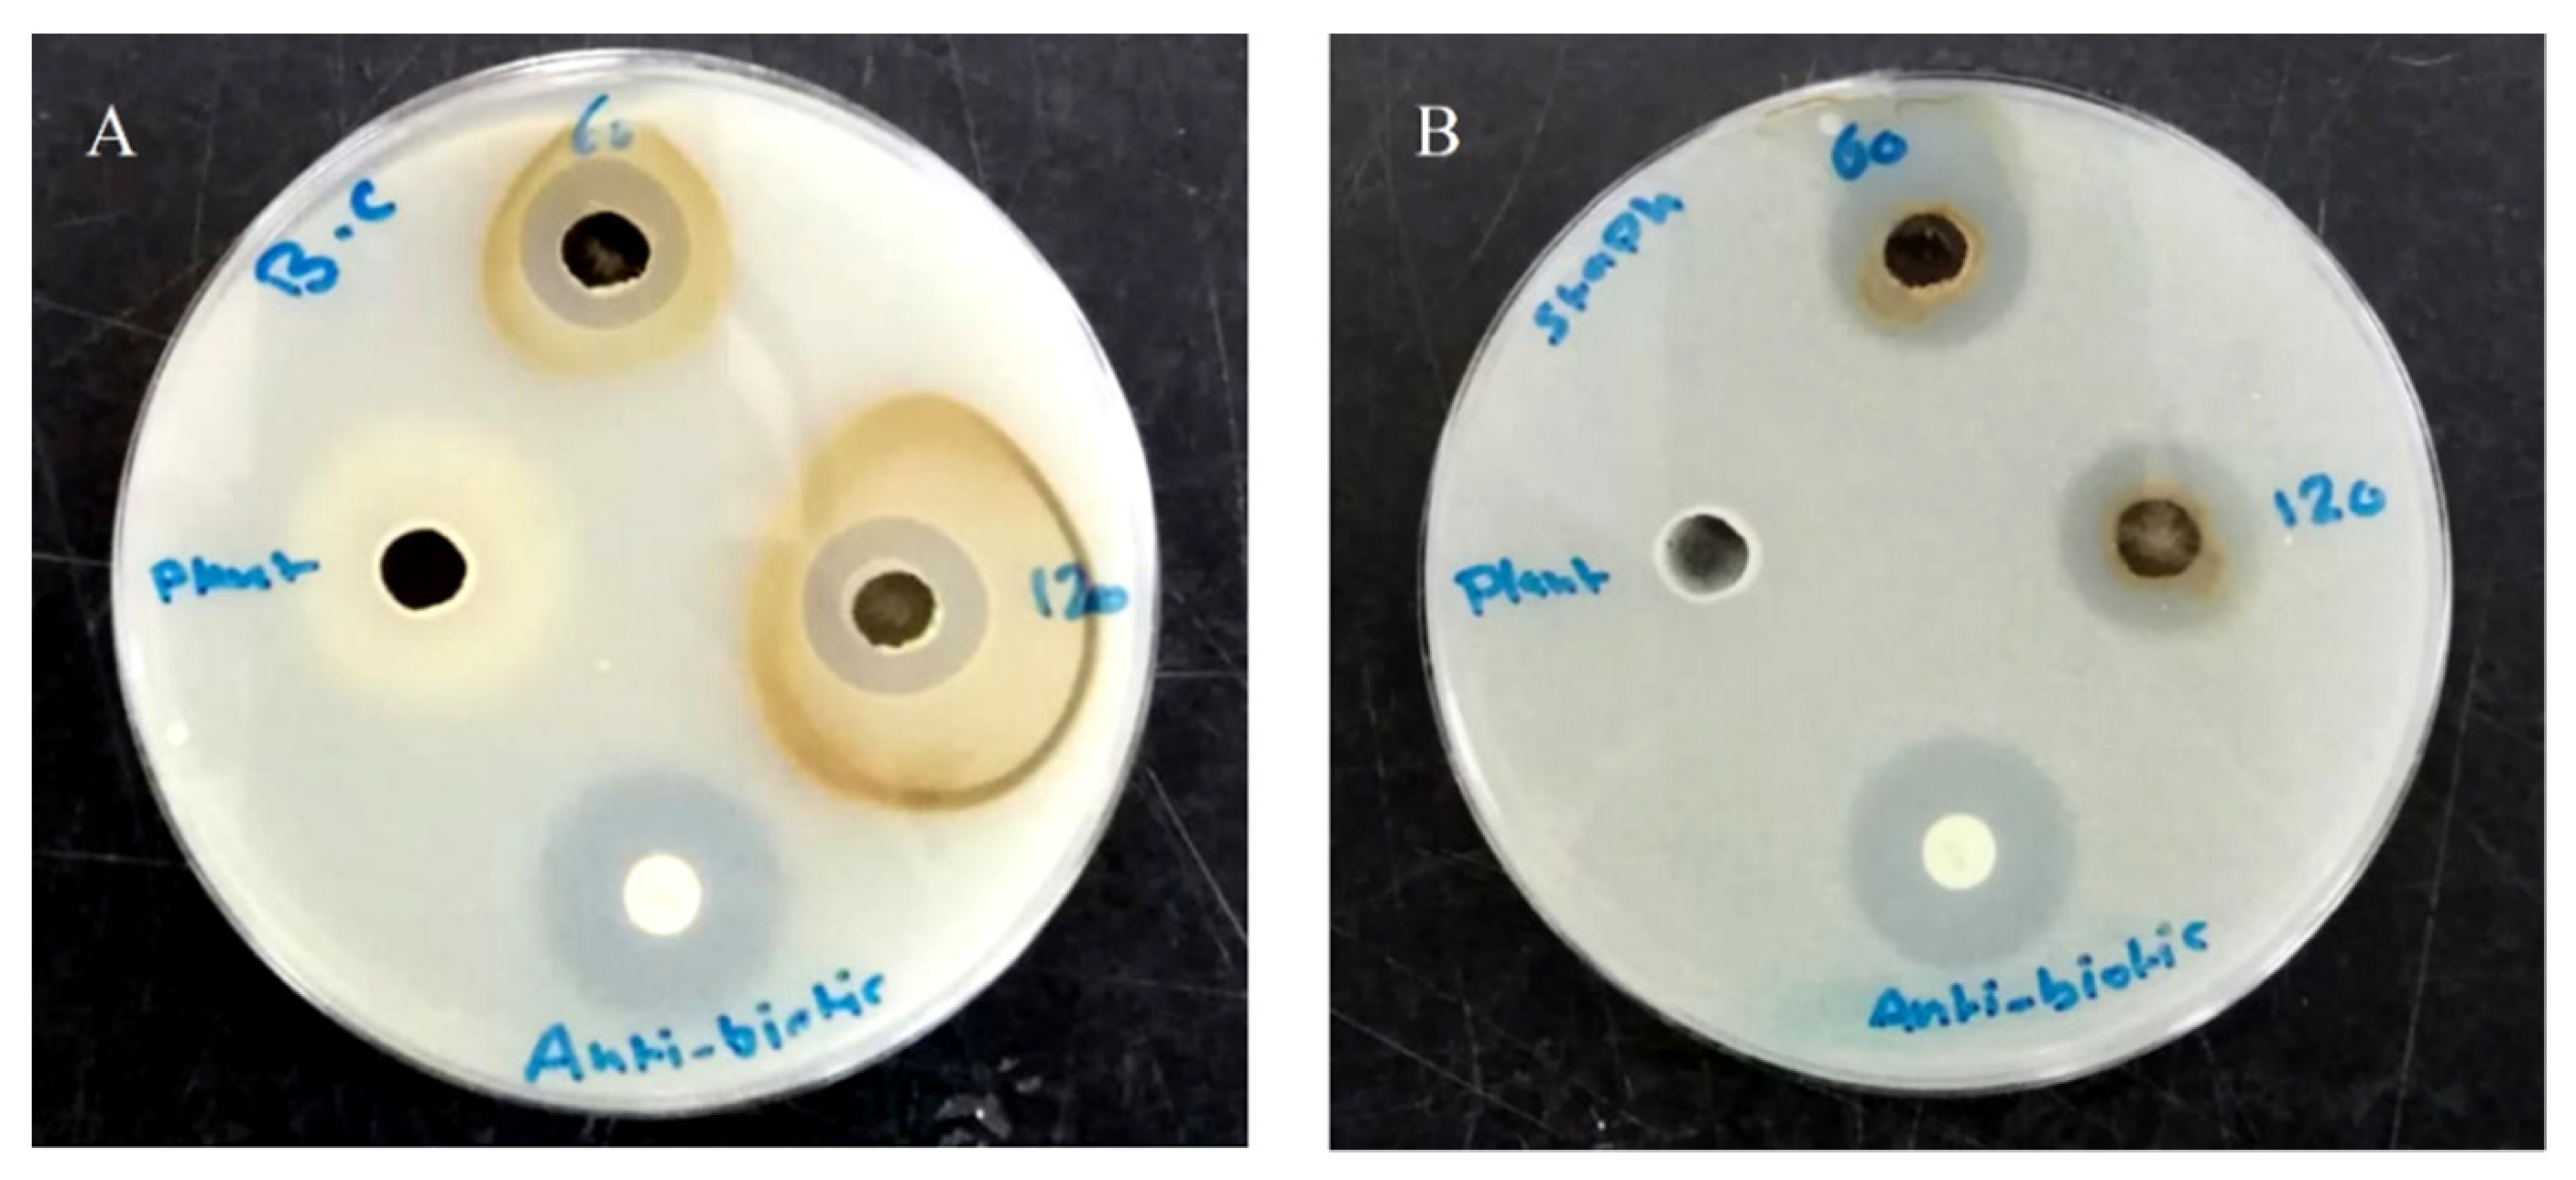
Pharmaceutics 14 01104 g004

Green Synthesis of Silver Nanoparticles Using Hypericum perforatum L. Aqueous Extract with the Evaluation of Its Antibacterial Activity against Clinical and Food Pathogens
Abstract
:1. Introduction
2. Materials and Methods
2.1. Chemicals and Instrumentation
2.2. Synthesis of Hypericum Perforatum L. aqueous Extract Mediated Silver Nanoparticles (AgNPs) and Their Chemical Characterization
2.3. Antibacterial Activity
2.4. Effect of AgNPs on Growth Kinetics of S. aureus
2.5. Estimation of Antibacterial Activity of AgNPs in Terms of CFU
2.6. Time-Kill Kinetics Assay
2.7. Wound Migration Assay
3. Result and Discussion
3.1. Chemical Characterization of Hypericum perforatum L. Phytochemicals-Capped AgNPs
3.2. Evaluation of Biological Activities of Hypericum perforatum Mediated AgNPs
4. Conclusions
Author Contributions
Funding
Institutional Review Board Statement
Informed Consent Statement
Data Availability Statement
Acknowledgments
Conflicts of Interest
References
- Khurana, A.; Tekula, S.; Saifi, M.A.; Venkatesh, P.; Godugu, C. Therapeutic applications of selenium nanoparticles. Biomed. Pharmacother. 2019, 111, 802–812. [Google Scholar] [CrossRef] [PubMed]
- Ikram, M.; Javed, B.; Raja, N.I.; Mashwani, Z.U.R. Biomedical potential of plant-based selenium nanoparticles: A comprehensive review on therapeutic and mechanistic aspects. Int. J. Nanomed. 2021, 16, 249–268. [Google Scholar] [CrossRef] [PubMed]
- Chinnasamy, G.; Chandrasekharan, S.; Koh, T.W.; Bhatnagar, S. Synthesis, characterization, antibacterial and wound healing efficacy of silver nanoparticles from Azadirachta indica. Front. Microbiol. 2021, 12, 611560. [Google Scholar] [CrossRef] [PubMed]
- Alahmad, A.; Feldhoff, A.; Bigall, N.C.; Rusch, P.; Scheper, T.; Walter, J.G. Hypericum perforatum L.-mediated green synthesis of silver nanoparticles exhibiting antioxidant and anticancer activities. Nanomaterials 2021, 11, 487. [Google Scholar] [CrossRef]
- Akintelu, S.A.; Bo, Y.; Folorunso, A.S. A review on synthesis, optimization, mechanism, characterization, and antibacterial application of silver nanoparticles synthesized from plants. J. Chem. 2020, 2020, 3189043. [Google Scholar] [CrossRef]
- El-Seedi, H.R.; El-Shabasy, R.M.; Khalifa, S.A.M.; Saeed, A.; Shah, A.; Shah, R.; Iftikhar, F.J.; Abdel-Daim, M.M.; Omri, A.; Hajrahand, N.H.; et al. Metal nanoparticles fabricated by green chemistry using natural extracts: Biosynthesis, mechanisms, and applications. RSC Adv. 2019, 9, 24539–24559. [Google Scholar] [CrossRef] [Green Version]
- Chandran, S.P.; Chaudhary, M.; Pasricha, R.; Ahmad, A.; Sastry, M. Synthesis of gold nanotriangles and silver nanoparticles using Aloe vera plant extract. Biotechnol. Prog. 2006, 22, 577–583. [Google Scholar] [CrossRef]
- Li, S.; Shen, Y.; Xie, A.; Yu, X.; Qiu, L.; Zhang, L.; Zhang, Q. Green synthesis of silver nanoparticles using Capsicum annuum L. extract. Green Chem. 2007, 9, 852–858. [Google Scholar] [CrossRef]
- Elumalai, E.; Prasad, T.; Hemachandran, J.; Therasa, S.V.; Thirumalai, T.; David, E. Extracellular synthesis of silver nanoparticles using leaves of Euphorbia hirta and their antibacterial activities. J. Pharm. Sci. Res. 2010, 2, 549–554. [Google Scholar]
- Krishnaraj, C.; Jagan, E.; Rajasekar, S.; Selvakumar, P.; Kalaichelvan, P.; Mohan, N. Synthesis of silver nanoparticles using Acalypha indica leaf extracts and its antibacterial activity against water borne pathogens. Colloids Surf. B Biointerfaces 2010, 76, 50–56. [Google Scholar] [CrossRef]
- Veerasamy, R.; Xin, T.Z.; Gunasagaran, S.; Xiang, T.F.W.; Yang, E.F.C.; Jeyakumar, N.; Dhanaraj, S.A. Biosynthesis of silver nanoparticles using mangosteen leaf extract and evaluation of their antimicrobial activities. J. Saudi Chem. Soc. 2011, 15, 113–120. [Google Scholar] [CrossRef] [Green Version]
- Khan, S.A.; Shahid, S.; Lee, C.-S. Green synthesis of gold and silver nanoparticles using leaf extract of Clerodendrum inerme; characterization, antimicrobial, and antioxidant activities. Biomolecules 2020, 10, 835. [Google Scholar] [CrossRef] [PubMed]
- Maghimaa, M.; Alharbi, S.A. Green synthesis of silver nanoparticles from Curcuma longa L. and coating on the cotton fabrics for antimicrobial applications and wound healing activity. J. Photochem. Photobiol. B Biol. 2020, 204, 111806. [Google Scholar] [CrossRef] [PubMed]
- Nilavukkarasi, M.; Vijayakumar, S.; Prathip Kumar, S. Biological synthesis and characterization of silver nanoparticles with Capparis zeylanica L. leaf extract for potent antimicrobial and anti proliferation efficiency. Mater. Sci. Energy Technol. 2020, 3, 371–376. [Google Scholar] [CrossRef]
- Olfati, A.; Kahrizi, D.; Balaky, S.T.J.; Sharifi, R.; Tahir, M.B.; Darvishi, E. Green synthesis of nanoparticles using Calendula officinalis extract from silver sulfate and their antibacterial effects on Pectobacterium caratovorum. Inorg. Chem. Commun. 2021, 125, 108439. [Google Scholar] [CrossRef]
- Jain, D.; Daima, H.K.; Kachhwaha, S.; Kothari, S. Synthesis of plant-mediated silver nanoparticles using papaya fruit extract and evaluation of their antimicrobial activities. Dig. J. Nanomater. Biostruct. 2009, 4, 557–563. [Google Scholar]
- Bar, H.; Bhui, D.K.; Sahoo, G.P.; Sarkar, P.; De, S.P.; Misra, A. Green synthesis of silver nanoparticles using latex of Jatropha curcas. Colloids Surf. A Physicochem. Eng. Asp. 2009, 339, 134–139. [Google Scholar] [CrossRef]
- Sathishkumar, M.; Sneha, K.; Won, S.W.; Cho, C.W.; Kim, S.; Yun, Y.S. Cinnamon zeylanicum bark extract and powder mediated green synthesis of nano-crystalline silver particles and its bactericidal activity. Colloids Surf. B Biointerfaces 2009, 73, 332–338. [Google Scholar] [CrossRef]
- Loo, Y.Y.; Rukayadi, Y.; Nor-Khaizura, M.-A.-R.; Kuan, C.H.; Chieng, B.W.; Nishibuchi, M.; Radu, S. In vitro antimicrobial activity of green synthesized silver nanoparticles against selected Gram-negative foodborne pathogens. Front. Microbiol. 2018, 9, 1555. [Google Scholar] [CrossRef]
- Paladini, F.; Pollini, M. Antimicrobial silver nanoparticles for wound healing application: Progress and future trends. Materials 2019, 12, 2540. [Google Scholar] [CrossRef] [Green Version]
- Yuwen, L.; Sun, Y.; Tan, G.; Xiu, W.; Zhang, Y.; Weng, L.; Teng, Z.; Wang, L. MoS2@polydopamine-Ag nanosheets with enhanced antibacterial activity for effective treatment of Staphylococcus aureus biofilms and wound infection. Nanoscale 2018, 10, 16711–16720. [Google Scholar] [CrossRef] [PubMed]
- Silvero, C.M.J.; Rocca, D.M.; de la Villarmois, E.A.; Fournier, K.; Lanterna, A.E.; Perez, M.F.; Becerra, M.C.; Scaiano, J.C. Selective photoinduced antibacterial activity of amoxicillin-coated gold nanoparticles: From one-step synthesis to in vivo cytocompatibility. ACS Omega 2018, 3, 1220–1230. [Google Scholar] [CrossRef] [PubMed]
- Dhas, T.S.; Kumar, V.G.; Karthick, V.A.; Angel, K.J.; Govindaraju, K. Facile synthesis of silver chloride nanoparticles using marine alga and its antibacterial efficacy. Spectrochim. Acta Part A Mol. Biomol. Spectrosc. 2014, 120, 416–420. [Google Scholar] [CrossRef] [PubMed]
- Das, C.A.; Kumar, V.G.; Dhas, T.S.; Karthick, V.; Govindaraju, K.; Joselin, J.M.; Baalamurugan, J. Antibacterial activity of silver nanoparticles (biosynthesis): A short review on recent advances. Biocatal. Agric. Biotechnol. 2020, 27, 101593. [Google Scholar] [CrossRef]
- Shanmuganathan, R.; Karuppusamy, I.; Saravanan, M.; Muthukumar, H.; Ponnuchamy, K.; Ramkumar, V.S.; Pugazhendhi, A. Synthesis of silver nanoparticles and their biomedical applications—A comprehensive review. Curr. Pharm. Des. 2019, 25, 2650–2660. [Google Scholar] [CrossRef]
- Kailasa, S.K.; Park, T.J.; Rohit, J.V.; Koduru, J.R. Antimicrobial activity of silver nanoparticles. In Nanoparticles in Pharmacotherapy, 1st ed.; Grumezescu, A.M., Ed.; William Andrew Pub., Elsevier: New York, NY, USA, 2019; Chapter 14; pp. 461–484. [Google Scholar] [CrossRef]
- Wei, L.; Lu, J.; Xu, H.; Patel, A.; Chen, Z.S.; Chen, G. Silver nanoparticles: Synthesis, properties, and therapeutic applications. Drug Discov. Today 2015, 20, 595–601. [Google Scholar] [CrossRef] [Green Version]
- Burdușel, A.C.; Gherasim, O.; Grumezescu, A.M.; Mogoantă, L.; Ficai, A.; Andronescu, E. Biomedical applications of silver nanoparticles: An up-to-date overview. Nanomaterials 2018, 8, 681. [Google Scholar] [CrossRef] [Green Version]
- Almatroudi, A. Silver nanoparticles: Synthesis, characterisation and biomedical applications. Open Life Sci. 2020, 15, 819–839. [Google Scholar] [CrossRef]
- Lenard, J.; Rabson, A.; Vanderoef, R. Photodynamic inactivation of infectivity of human immunodeficiency virus and other enveloped viruses using hypericin and rose bengal: Inhibition of fusion and syncytia formation. Proc. Natl. Acad. Sci. USA 1993, 90, 158–162. [Google Scholar] [CrossRef] [Green Version]
- Davidson, J.R.T.; Connor, K.M. John’s wort in generalized anxiety disorder: Three case reports. J. Clin. Psychopharmacol. 2001, 21, 635–636. [Google Scholar] [CrossRef]
- Bukhari, I.A.; Dar, A.; Khan, R.A. Antinociceptive activity of methanolic extracts of St. John’s Wort (Hypericum perforatum) preparation. Pak. J. Pharm. Sci. 2004, 17, 13–19. [Google Scholar] [PubMed]
- Schepetkin, I.A.; Özek, G.; Özek, T.; Kirpotina, L.N.; Khlebnikov, A.I.; Quinn, M.T. Chemical composition and immunomodulatory activity of Hypericum perforatum essential oils. Biomolecules 2020, 10, 916. [Google Scholar] [CrossRef] [PubMed]
- Shafaghat, A. Antioxidant, antimicrobial activities and fatty acid components of flower, leaf, stem and seed of Hypericum scabrum. Nat. Prod. Commun. 2011, 6, 1739–1742. [Google Scholar] [CrossRef] [PubMed] [Green Version]
- Derun, E.M.; Eslek, Z.; Piskin, S. Evaluation of analysis on the extracts from Hypericum perforatum L. grown in Turkey. Int. J. Chem. Nucl. Metall. Mater. Eng. 2013, 7, 263–266. [Google Scholar]
- Upton, R.; Upton, R.; Pharmacopoeia, A.H.; Cott, J.; Williamson, E.; St. Graff, A. John’s Wort: Hypericum Perforatum: Quality Control, Analytical and Therapeutic Monograph; American Herbal Pharmacopoeia: Boca Raton, FL, USA, 1997. [Google Scholar]
- Lavie, G.; Mazur, Y.; Lavie, D.; Prince, A.; Pascual, D.; Liebes, L.; Levin, B.; Meruelo, D. Hypericin as an inactivator of infectious viruses in blood components. Transfusion 1995, 35, 392–400. [Google Scholar] [CrossRef] [PubMed]
- Lakmann, G.; Schule, C.; Baghai, T.; Kieser, M. St. John’s Wort in mild to moderate depression: The relevance of hyperforin for the clinical efficacy. Pharmacopsychiatry 1998, 31, 54–59. [Google Scholar] [CrossRef] [PubMed]
- Zou, Y.; Lu, Y.; Wei, D. Antioxidant activity of a flavonoid-rich extract of Hypericum perforatum L. in vitro. J. Agric. Food Chem. 2004, 52, 5032–5039. [Google Scholar] [CrossRef]
- Saddiqe, Z.; Naeem, I.; Maimoona, A. A review of the antibacterial activity of Hypericum perforatum L. J. Ethnopharmacol. 2010, 131, 511–521. [Google Scholar] [CrossRef]
- Gitea, D.; Teodorescu, A.; Pantis, C.; Tit, D.M.; Bungau, A.F.; Bogdan, M.; Fodor, I.K.; Bustea, C. Green synthesis of silver nanoparticles using Hypericum perforatum L. extract and evaluation of their antibacterial activity. Rev. Chim. 2020, 71, 273–279. [Google Scholar] [CrossRef]
- Ozgen, A.; Bilgic, E.; Aydin, S.G.; Nizamlioglu, M. Characterization of biosynthesized silver nanoparticles using Hypericum perforatum leaf and determination of their antibacterial activity. Med. Sci. 2019, 8, 503–507. [Google Scholar] [CrossRef]
- Prakash, D.J.; Arulkumar, S.; Sabesan, M. Effect of nanohypericum (Hypericum perforatum gold nanoparticles) treatment on restraint stress-induced behavioral and biochemical alteration in male albino mice. Pharmacogn. Res. 2010, 2, 330–334. [Google Scholar] [CrossRef] [Green Version]
- Jafarizad, A.; Safaee, K.; Vahid, B.; Khataee, A.; Ekinci, D. Synthesis and characterization of gold nanoparticles using Hypericum perforatum and Nettle aqueous extracts: A comparison with turkevich method. Environ. Prog. Sustain. Energy 2019, 38, 508–517. [Google Scholar] [CrossRef]
- Pradeep, M.; Kruszka, D.; Kachlicki, P.; Mondal, D.; Franklin, G. Uncovering the phytochemical basis and the mechanism of plant extract-mediated eco-friendly synthesis of silver nanoparticles using ultra-performance liquid chromatography coupled with a photodiode array and high-resolution mass spectrometry. ACS Sustain. Chem. Eng. 2022, 10, 562–571. [Google Scholar] [CrossRef]
- Alahmad, A.; Alghoraibi, I.; Zein, R.; Kraft, S.; Dräger, G.; Walter, J.; Scheper, T. Identification of major constituents of Hypericum perforatum L. extracts in Syria by development of a rapid, simple and reproducible HPLC-ESI-Q-TOF MS analysis and their antioxidant activities. ACS Omega 2022, 7, 13475–13493. [Google Scholar] [CrossRef]
- Al-Zereini, W.A. Bioactive crude extracts from four bacterial isolates of marine sediments from Red Sea, Gulf of Aqaba, Jordan. Jord. J. Biol. Sci. 2014, 7, 133–137. [Google Scholar] [CrossRef] [Green Version]
- CLSI. Performance Standards for Antimicrobial Susceptibility Testing; Twenty-Second Informational Supplement, M100-S22; Clinical and Laboratory Standards Institute: Wayne, PA, USA, 2012. [Google Scholar]
- Wadhwani, S.; Gorain, M.; Banerjee, P.; Shedbalkar, U.; Singh, R.; Kundu, G.; Chopade, B. Green synthesis of selenium nanoparticles using Acinetobacter sp. SW30: Optimization, characterization and its anticancer activity in breast cancer cells. Int. J. Nanomed. 2017, 12, 6841–6855. [Google Scholar] [CrossRef] [Green Version]
- Ma, L.; Su, W.; Liu, J.X.; Zeng, X.X.; Huang, Z.; Li, W.; Liu, Z.C.; Tang, J.X. Optimization for extracellular biosynthesis of silver nanoparticles by Penicillium aculeatum Su1 and their antimicrobial activity and cytotoxic effect compared with silver ions. Mater. Sci. Eng. C Mater. Biol. Appl. 2017, 77, 963–971. [Google Scholar] [CrossRef]
- Rolim, W.R.; Pelegrino, M.T.; de Araújo Lima, B.; Ferraz, L.S.; Costa, F.N.; Bernardes, J.S.; Rodigues, T.; Brocchi, M.; Seabra, A.B. Green tea extract mediated biogenic synthesis of silver nanoparticles: Characterization, cytotoxicity evaluation and antibacterial activity. Appl. Surf. Sci. 2019, 463, 66–74. [Google Scholar] [CrossRef]
- Ernawati; Suprayitno, E.; Hardoko; Yanuhar, U. Extraction of bioactive compounds fruit from Rhizophora mucronata using sonication method. IOP Conf. Ser. Earth Environ. Sci. 2019, 236, 012122. [Google Scholar] [CrossRef]
- Jarzębski, M.; Smułek, W.; Baranowska, H.M.; Masewicz, Ł.; Kobus-Cisowska, J.; Ligaj, M.; Kaczorek, E. Characterization of St. John’s wort (Hypericum perforatum L.) and the impact of filtration process on bioactive extracts incorporated into carbohydrate-based hydrogels. Food Hydrocoll. 2020, 104, 105748. [Google Scholar] [CrossRef]
- Alim-Al-Razy, M.; Asik Bayazid, G.M.; Rahman, R.U.; Bosu, R.; Shamma, S.S. Silver nanoparticle synthesis, UV-Vis spectroscopy to find particle size and measure resistance of colloidal solution. J. Phys. Conf. Ser. 2020, 1706, 012020. [Google Scholar] [CrossRef]
- Aziz, S.B.; Abdullah, O.G.; Saber, D.R.; Rasheed, M.A.; Ahmed, H.M. Investigation of metallic silver nanoparticles through UV-Vis and optical micrograph techniques. Int. J. Electrochem. Sci. 2017, 12, 363–373. [Google Scholar] [CrossRef]
- Shankar, S.S.; Rai, A.; Ahmad, A.; Sastry, M. Rapid synthesis of Au, Ag, and bimetallic Au core–Ag shell nanoparticles using Neem (Azadirachta indica) leaf broth. J. Colloid Interface Sci. 2004, 275, 496–502. [Google Scholar] [CrossRef]
- Marslin, G.; Selvakesavan, R.K.; Franklin, G.; Sarmento, B.; Dias, A.C. Antimicrobial activity of cream incorporated with silver nanoparticles biosynthesized from Withania somnifera. Int. J. Nanomed. 2015, 10, 5955–5963. [Google Scholar]
- Gontijo, L.A.; Raphael, E.; Ferrari, D.P.; Ferrari, J.L.; Lyon, J.P.; Schiavon, M.A. pH effect on the synthesis of different size silver nanoparticles evaluated by DLS and their size-dependent antimicrobial activity. Matéria (Rio Jan.) 2020, 25, e-12845. [Google Scholar] [CrossRef]
- Gunti, L.; Dass, R.S.; Kalagatur, N.K. Phytofabrication of selenium nanoparticles from Emblica officinalis fruit extract and exploring its biopotential applications: Antioxidant, antimicrobial, and biocompatibility. Front. Microbiol. 2019, 10, 931. [Google Scholar] [CrossRef] [PubMed] [Green Version]
- Pyrzynska, K.; Sentkowska, A. Biosynthesis of selenium nanoparticles using plant extracts. J. Nanostructure Chem. 2021, 28, 1–4. [Google Scholar] [CrossRef]
- Chandran, P.R.; Naseer, M.; Udupa, N.; Sandhyarani, N. Size controlled synthesis of biocompatible gold nanoparticles and their activity in the oxidation of NADH. Nanotechnology 2012, 23, 015602. [Google Scholar] [CrossRef] [PubMed]
- Haroon, H.; Kulandhaivel, M.; Anbalagan, S.; Sankareswaran, M.; Abirami, K.; Prabhavathi, P.; Manikandan, A. Green synthesis of silver nanoparticles using Hybanthus enneaspermus plant extract against nosocomial pathogens with nanofinished antimicrobial cotton fabric. Glob. J. Nanomed. 2017, 1, 555554. [Google Scholar] [CrossRef]
- Margoshes, M.; Fassel, V.A. The infrared spectra of aromatic compounds: I. The out-of-plane C-H bending vibrations in the region 625–900 cm−1. Spectrochim. Acta 1955, 7, 14–24. [Google Scholar] [CrossRef]
- Lehto, J.; Louhelainen, J.; Kłosińska, T.; Drożdżek, M.; Alén, R. Characterization of alkali-extracted wood by FTIR-ATR spectroscopy. Biomass Convers. Biorefin. 2018, 8, 847–855. [Google Scholar] [CrossRef]
- Ashokkumar, R.; Ramaswamy, M. Phytochemical screening by FTIR spectroscopic analysis of leaf extracts of selected Indian medicinal plants. Int. J. Curr. Microbiol. Appl. Sci. 2014, 3, 395–406. [Google Scholar]
- Petković, M. O–H stretch in phenol and its hydrogen-bonded complexes: Band position and relaxation pathways. J. Phys. Chem. A 2012, 116, 364–371. [Google Scholar] [CrossRef] [PubMed]
- Brangule, A.; Šukele, R.; Bandere, D. Herbal medicine characterization perspectives using advanced FTIR sample techniques—diffuse reflectance (DRIFT) and photoacoustic spectroscopy (PAS). Front. Plant Sci. 2020, 11, 356. [Google Scholar] [CrossRef]
- Ahmad, T.; Wani, I.A.; Manzoor, N.; Ahmed, J.; Asiri, A.M. Biosynthesis, structural characterization and antimicrobial activity of gold and silver nanoparticles. Colloids Surf. B Biointerfaces. 2013, 107, 227–234. [Google Scholar] [CrossRef]
- Begam, J.N. Biosynthesis and characterization of silver nanoparticles (AgNPs) using marine bacteria against certain human pathogens. Int. J. Adv. Sci. Res. 2016, 2, 152–156. [Google Scholar] [CrossRef] [Green Version]
- Anigol, L.B.; Charantimath, J.S.; Gurubasavaraj, P.M. Effect of concentration and pH on the size of silver nanoparticles synthesized by green chemistry. Org. Med. Chem. Int. J. 2017, 3, 1–5. [Google Scholar] [CrossRef]
- Mondal, A.; Hajra, A.; Shaikh, W.A.; Chakraborty, S.; Mondal, N.K. Synthesis of silver nanoparticle with Colocasia esculenta (L.) stem and its larvicidal activity against Culex quinquefasciatus and Chironomus sp. Asian Pac. J. Trop. Biomed. 2019, 9, 510–517. [Google Scholar] [CrossRef]
- Philip, D. Biosynthesis of Au, Ag and Au–Ag nanoparticles using edible mushroom extract. Spectrochim. Acta Part A Mol. Biomol. Spectrosc. 2009, 73, 374–381. [Google Scholar] [CrossRef]
- Vijai Anand, K.; Reshma, M.; Kannan, M.; Muthamil Selvan, S.; Chaturvedi, S.; Shalan, A.E.; Govindaraju, K. Preparation and characterization of calcium oxide nanoparticles from marine molluscan shell waste as nutrient source for plant growth. J. Nanostructure Chem. 2021, 11, 409–422. [Google Scholar] [CrossRef]
- Urnukhsaikhan, E.; Bold, B.E.; Gunbileg, A.; Sukhbaatar, N.; Mishig-Ochir, T. Antibacterial activity and characteristics of silver nanoparticles biosynthesized from Carduus crispus. Sci. Rep. 2021, 11, 21047. [Google Scholar] [CrossRef] [PubMed]
- Dastagir, G.; Ahmed, R.; Shereen, S. Elemental, nutritional, phytochemical and biological evaluation of Hypericum perforatum Linn. Pak. J. Pharm. Sci. 2016, 29, 547–555. [Google Scholar] [PubMed]
- Sagadevan, S.; Vennila, S.; Singh, P.; Lett, J.A.; Johan, M.R.; Muthiah, B.; Lakshmipathy, M. Facile synthesis of silver nanoparticles using Averrhoa bilimbi L and Plum extracts and investigation on the synergistic bioactivity using in vitro models. Green Process. Synth. 2019, 8, 873–884. [Google Scholar] [CrossRef]
- Ivashchenko, O.; Przysiecka, Ł.; Peplinska, B.; Flak, D.; Coy, E.; Jarek, M.; Zalewski, T.; Musiał, A.; Jurga, S. Organic–inorganic hybrid nanoparticles synthesized with Hypericum perforatum extract: Potential agents for photodynamic therapy at ultra-low power light. ACS Sustain. Chem. Eng. 2021, 9, 1625–1645. [Google Scholar] [CrossRef]
- Fernandes, F.H.; Santana, C.P.; Santos, R.L.; Correia, L.P.; Conceição, M.M.; Macêdo, R.O.; Medeiros, A.C. Thermal characterization of dried extract of medicinal plant by DSC and analytical techniques. J. Therm. Anal. Calorim. 2013, 113, 443–447. [Google Scholar] [CrossRef]
- Saware, K.; Sawle, B.; Salimath, B.; Jayanthi, K.; Abbaraju, V. Biosynthesis and characterization of silver nanoparticles using Ficus benghalensis leaf extract. Int. J. Res. Eng. Technol. 2014, 3, 867–874. [Google Scholar]
- Menon, S.; Agarwal, H.; Kumar, S.R.; Kumar, S.V. Green synthesis of silver nanoparticles using medicinal plant Acalypha indica leaf extracts and its application as an antioxidant and antimicrobial agent against foodborne pathogens. Int. J. Appl. Pharm. 2017, 9, 42–50. [Google Scholar] [CrossRef] [Green Version]
- Filipe, V.; Hawe, A.; Jiskoot, W. Critical evaluation of nanoparticle tracking analysis (NTA) by nanosight for the measurement of nanoparticles and protein aggregates. Pharm. Res. 2010, 27, 796–810. [Google Scholar] [CrossRef] [Green Version]
- Fan, Y.; Sahdev, P.; Ochyl, L.J.; Akerberg, J.J.; Moon, J.J. Cationic liposome-hyaluronic acid hybrid nanoparticles for intranasal vaccination with subunit antigens. J. Control. Release 2015, 208, 121–129. [Google Scholar] [CrossRef] [Green Version]
- Lee, S.H.; Jun, B.-H. Silver nanoparticles: Synthesis and application for nanomedicine. Int. J. Mol. Sci. 2019, 20, 865. [Google Scholar] [CrossRef] [Green Version]
- Manoj, L.; Vishwakarma, V.; Samal, S.S.; Seeni, S. Green synthesis of silver nanoparticles using hypericin-rich shoot cultures of Hypericum hookerianum and evaluation of anti-bacterial activities. J. Exp. Nanosci. 2015, 10, 181–188. [Google Scholar] [CrossRef]
- Nazari, Z.; Shafaghat, A. Biological synthesis and antimicrobial activity of nano-silver using Hypericum scabrum seed extract. Inorg. Nano-Met. Chem. 2017, 47, 870–875. [Google Scholar] [CrossRef]
- Shaik, M.R.; Khan, M.; Kuniyil, M.; Al-Warthan, A.; Alkhathlan, H.Z.; Siddiqui, M.R.H.; Shaik, J.P.; Ahamed, A.; Mahmood, A.; Khan, M.; et al. Plant-extract-assisted green synthesis of silver nanoparticles using Origanum vulgare L. extract and their microbicidal activities. Sustainability 2018, 10, 913. [Google Scholar] [CrossRef] [Green Version]
- Rathnayake, W.G.I.U.; Ismail, H.; Baharin, A.; Darsanasiri, A.G.N.D.; Rajapakse, S. Synthesis and characterization of nano-silver based natural rubber latex foam for imparting antibacterial and anti-fungal properties. Polym. Test. 2012, 31, 586–592. [Google Scholar] [CrossRef]
- Padalia, H.; Moteriya, P.; Chanda, S. Green synthesis of silver nanoparticles from marigold flower and its synergistic antimicrobial potential. Arab. J. Chem. 2015, 8, 732–741. [Google Scholar] [CrossRef] [Green Version]
- Gomathi, M.; Rajkumar, P.V.; Prakasam, A.; Ravichandran, K. Green synthesis of silver nanoparticles using Datura stramonium leaf extract and assessment of their antibacterial activity. Resour.-Effic. Technol. 2017, 3, 280–284. [Google Scholar] [CrossRef]
- Khandel, P.; Shahi, S.K.; Soni, D.K.; Yadaw, R.K.; Kanwar, L. Alpinia calcarata: Potential source for the fabrication of bioactive silver nanoparticles. Nano Converg. 2018, 5, 37. [Google Scholar] [CrossRef]
- Kim, J.S.; Kuk, E.; Yu, K.N.; Kim, J.H.; Park, S.J.; Lee, H.J.; Kim, S.H.; Park, Y.K.; Park, Y.H.; Hwang, C.Y.; et al. Antimicrobial effects of silver nanoparticles. Nanomed. Nanotechnol. Biol. Med. 2007, 3, 95–101. [Google Scholar] [CrossRef]
- Ghetas, H.A.; Abdel-Razek, N.; Shakweer, M.S.; Abotaleb, M.M.; Paray, B.A.; Ali, S.; Eldessouki, E.A.; Dawood, M.A.; Khalil, R.H. Antimicrobial activity of chemically and biologically synthesized silver nanoparticles against some fish pathogens. Saudi J. Biol. Sci. 2022, 29, 1298–1305. [Google Scholar] [CrossRef]
- Wang, H.; Yan, A.; Liu, Z.; Yang, X.; Xu, Z.; Wang, Y.; Wang, R.; Koohi-Moghadam, M.; Hu, L.; Xia, W.; et al. Deciphering molecular mechanism of silver by integrated omic approaches enables enhancing its antimicrobial efficacy in E. coli. PLoS Biol. 2019, 17, e3000292. [Google Scholar] [CrossRef] [Green Version]
- Khan, S.U.; Saleh, T.A.; Wahab, A.; Khan, M.H.U.; Khan, D.; Khan, W.U.; Rahim, A.; Kamal, S.; Khan, F.U.; Fahad, S. Nanosilver: New ageless and versatile biomedical therapeutic scaffold. Int. J. Nanomed. 2018, 13, 733–762. [Google Scholar] [CrossRef] [Green Version]
- Siddiqi, K.S.; Husen, A.; Rao, R.A. A review on biosynthesis of silver nanoparticles and their biocidal properties. J. Nanobiotechnology 2018, 16, 14. [Google Scholar] [CrossRef] [PubMed]
- Kambale, E.K.; Nkanga, C.I.; Mutonkole, B.P.; Bapolisi, A.M.; Tassa, D.O.; Liesse, J.M.; Krause, R.W.; Memvanga, P.B. Green synthesis of antimicrobial silver nanoparticles using aqueous leaf extracts from three Congolese plant species (Brillantaisia patula, Crossopteryx febrifuga and Senna siamea). Heliyon 2020, 6, e04493. [Google Scholar] [CrossRef] [PubMed]
- Al-Zereini, W.A. Ononis natrix and Salvia verbenaca: Two Jordanian medicinal plants with cytotoxic and antibacterial activities. J. Herbs Spices Med. Plants 2017, 23, 18–25. [Google Scholar] [CrossRef]
- Vijayan, R.; Joseph, S.; Mathew, B. Green synthesis, characterization and applications of noble metal nanoparticles using Myxopyrum serratulum A. W. Hill leaf extract. BioNanoScience 2018, 8, 105–117. [Google Scholar] [CrossRef]
- Abou El-Nour, K.M.; Eftaiha, A.A.; Al-Warthan, A.; Ammar, R.A. Synthesis and applications of silver nanoparticles. Arab. J. Chem. 2010, 3, 135–140. [Google Scholar] [CrossRef] [Green Version]
- Quinteros, M.A.; Aristizábal, V.C.; Dalmasso, P.R.; Paraje, M.G.; Páez, P.L. Oxidative stress generation of silver nanoparticles in three bacterial genera and its relationship with the antimicrobial activity. Toxicol. In Vitr. 2016, 36, 216–223. [Google Scholar] [CrossRef]
- Liao, S.; Zhang, Y.; Pan, X.; Zhu, F.; Jiang, C.; Liu, Q.; Cheng, Z.; Dai, G.; Wu, G.; Wang, L.; et al. Antibacterial activity and mechanism of silver nanoparticles against multidrug-resistant Pseudomonas aeruginosa. Int. J. Nanomed. 2019, 14, 1469–1487. [Google Scholar] [CrossRef] [Green Version]
- de Araújo Vieira, L.F.; Lins, M.P.; Viana, I.M.; Dos Santos, J.E.; Smaniotto, S.; dos Santos Reis, M.D. Metallic nanoparticles reduce the migration of human fibroblasts in vitro. Nanoscale Res. Lett. 2017, 12, 200. [Google Scholar] [CrossRef] [Green Version]
- Liu, X.; Lee, P.Y.; Ho, C.M.; Lui, V.C.; Chen, Y.; Che, C.M.; Tam, P.K.; Wong, K.K. Silver nanoparticles mediate differential responses in keratinocytes and fibroblasts during skin wound healing. ChemMedChem 2010, 5, 468–475. [Google Scholar] [CrossRef] [Green Version]
- Gunasekaran, T.; Nigusse, T.; Dhanaraju, M.D. Silver nanoparticles as real topical bullets for wound healing. J. Am. Coll. Clin. Wound Spec. 2011, 3, 82–96. [Google Scholar] [CrossRef] [PubMed] [Green Version]
- Vijayakumar, V.; Samal, S.K.; Mohanty, S.; Nayak, S.K. Recent advancements in biopolymer and metal nanoparticle-based materials in diabetic wound healing management. Int. J. Biol. Macromol. 2019, 122, 137–148. [Google Scholar] [CrossRef] [PubMed]
- Rigo, C.; Ferroni, L.; Tocco, I.; Roman, M.; Munivrana, I.; Gardin, C.; Cairns, W.R.; Vindigni, V.; Azzena, B.; Barbante, C.; et al. Active silver nanoparticles for wound healing. Int. J. Mol. Sci. 2013, 14, 4817–4840. [Google Scholar] [CrossRef] [PubMed] [Green Version]

| Bacterial Strain | Inhibition Zone (mm ± SD) (µg/Well) | S (10 µg/Disc) | MIC (µg/mL) | ||
|---|---|---|---|---|---|
| 50 | 100 | AgNPs | S | ||
| Gram-positive | |||||
| B. subtilis | 11.7 ± 0.6 | 13.3 ± 0.6 | 23.3 ± 1.6 | 12.5 c | 0.63 s |
| B. cereus | 19.0 ± 1 | 24.3 ± 2.1 | 29.7 ± 1.3 | 6.25 s | 0.31 s |
| S. aureus | 27.7 ± 1.5 | 32.0 ± 1.3 | 31.3 ± 0.7 | 12.5 c | 0.63 c |
| Gram-negative | |||||
| E. coli | NA | NA | 18.0 ± 1.3 | >100 | 5 c |
| E. coli (clinical) | NA | NA | 12.3 ± 0.7 | >100 | >10 |
| K. pneumonia (clinical) | 10.3 ± 0.6 | 13 ± 1 | 15.7 ± 0.7 | 12.5 c | 10 c |
| P. aeruginosa | 16.7 ± 1.5 | 19.7 ± 1.1 | 17.1 ± 0.3 | 6.25 s | 2.5 s |
| Concentration (µg/mL) | Specific Growth Rate (h−1) | Maximum Growth Intensity (OD600nm) |
|---|---|---|
| Control | 0.43 ± 0.027 | 1.08 ± 0.05 |
| 1 | 0.20 ± 0.015 | 1.04 ± 0.07 |
| 3 | 0.13 ± 0.008 | 0.84 ± 0.04 |
| 6 | 0.10 ± 0.011 | 0.58 ± 0.03 |
| 12 | - | 0.07 ± 0.01 |
| 24 | - | 0.032 ± 0.007 |
Publisher’s Note: MDPI stays neutral with regard to jurisdictional claims in published maps and institutional affiliations. |
© 2022 by the authors. Licensee MDPI, Basel, Switzerland. This article is an open access article distributed under the terms and conditions of the Creative Commons Attribution (CC BY) license (https://creativecommons.org/licenses/by/4.0/).
Share and Cite
Alahmad, A.; Al-Zereini, W.A.; Hijazin, T.J.; Al-Madanat, O.Y.; Alghoraibi, I.; Al-Qaralleh, O.; Al-Qaraleh, S.; Feldhoff, A.; Walter, J.-G.; Scheper, T. Green Synthesis of Silver Nanoparticles Using Hypericum perforatum L. Aqueous Extract with the Evaluation of Its Antibacterial Activity against Clinical and Food Pathogens. Pharmaceutics 2022, 14, 1104. https://doi.org/10.3390/pharmaceutics14051104
Alahmad A, Al-Zereini WA, Hijazin TJ, Al-Madanat OY, Alghoraibi I, Al-Qaralleh O, Al-Qaraleh S, Feldhoff A, Walter J-G, Scheper T. Green Synthesis of Silver Nanoparticles Using Hypericum perforatum L. Aqueous Extract with the Evaluation of Its Antibacterial Activity against Clinical and Food Pathogens. Pharmaceutics. 2022; 14(5):1104. https://doi.org/10.3390/pharmaceutics14051104
Chicago/Turabian StyleAlahmad, Abdalrahim, Wael A. Al-Zereini, Tahani J. Hijazin, Osama Y. Al-Madanat, Ibrahim Alghoraibi, Omar Al-Qaralleh, Samer Al-Qaraleh, Armin Feldhoff, Johanna-Gabriela Walter, and Thomas Scheper. 2022. "Green Synthesis of Silver Nanoparticles Using Hypericum perforatum L. Aqueous Extract with the Evaluation of Its Antibacterial Activity against Clinical and Food Pathogens" Pharmaceutics 14, no. 5: 1104. https://doi.org/10.3390/pharmaceutics14051104
APA StyleAlahmad, A., Al-Zereini, W. A., Hijazin, T. J., Al-Madanat, O. Y., Alghoraibi, I., Al-Qaralleh, O., Al-Qaraleh, S., Feldhoff, A., Walter, J.-G., & Scheper, T. (2022). Green Synthesis of Silver Nanoparticles Using Hypericum perforatum L. Aqueous Extract with the Evaluation of Its Antibacterial Activity against Clinical and Food Pathogens. Pharmaceutics, 14(5), 1104. https://doi.org/10.3390/pharmaceutics14051104

